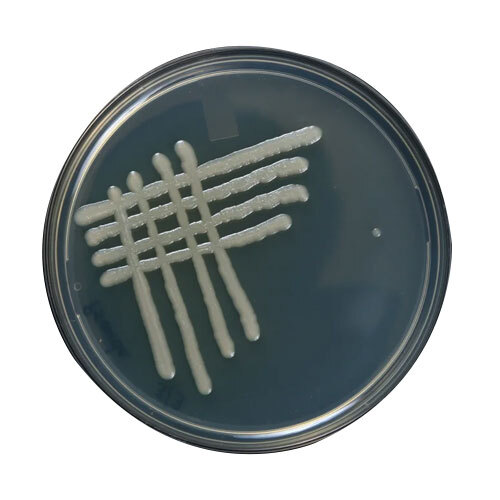

Ankleshwar, Gujarat, India|GST 24AAPCA1856J2ZF
Anbr Elixir Private Limited - Dextrose Carrier Base Bio Pesticide (9)
GST
24AAPCA1856J2ZF
Rating
3
Marketing Executive
Mrs Dhara Patel
Address
Plot No. 5144, Nr. Prime Industries, Seven Water Tank Road, Paras Chowkdi, GIDC Estate, Ankleshwar, Gujarat, 393002, India
Prominent & leading Exporter from Ankleshwar, we supply finest quality Dextrose Carrier Base Bio Pesticide including Nematodes Free Dextrose Carrier, Beauveria Bassiana Dextrose Carrier, Trichoderma Viride as per client requirements.
All Categories
Seller Details
Rating
3
Marketing Executive
Mrs Dhara Patel
Address
Plot No. 5144, Nr. Prime Industries, Seven Water Tank Road, Paras Chowkdi, GIDC Estate, Ankleshwar, Gujarat, 393002, India
Get the Best Price for
Anbr Elixir Private LimitedRegister your
Company
Popular Products
Human HairForklift TrucksServo Voltage StabilizerBasmati RiceBackhoe LoaderCarry Bag Making MachineDrum LifterElectric StackerScissor LiftsIndustrial Vibrating ScreenRotameterFlowmeterRotary Air CompressorIndustrial Eto SterilizerRice Packaging MachinesShredding MachineHammer MillAutomatic Labelling MachineDiesel ForkliftAerial Work PlatformStorage Rack SystemEpoxy ResinMild Steel BarStainless Steel SheetsStainless Steel StripsBag Filling MachinesAsphalt PlantsSlat ConveyorOintment PlantPlanetary MixersLadies KurtisLed LightsCctv CameraBall ValveAnti Cancer MedicineAir CompressorIncense SticksSolar LightsGoods LiftsVitrified TilesStainless Steel CoilsPvc PipesPvc Pipe FittingsUpvc PipesUpvc Ball ValvePipe Elbows